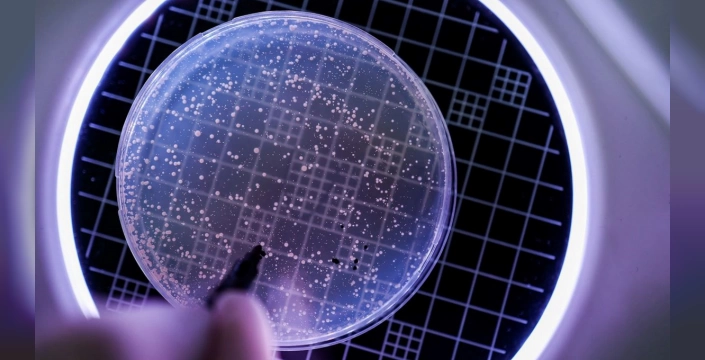

Evrensel bağışıklık mümkün mü?: Tüm virüslere karşı koruyucu ilaç geliştirildi
Columbia Üniversitesi'ndeki bilim insanları, mRNA teknolojisiyle birleştirilen ender bir genetik mutasyon kullanarak, tüm virüslere karşı koruma sağlayan bir ilaç geliştirdi.
Bilim insanları, mRNA teknolojisiyle birleştirilen ender bir genetik mutasyon kullanarak, tüm virüslere karşı vücudu koruyan bir ilaç geliştirdiklerini duyurdu. Columbia Üniversitesi araştırmacıları tarafından yapılan çalışmada, ISG15 genindeki nadir bir mutasyonun, virüslere karşı koruyucu etkileri araştırıldı.
Çığır AçAN KEŞİF
Araştırmacılar, bu mutasyonun dört güne kadar neredeyse tüm virüslere karşı koruma sağladığını tespit etti. 2018'de keşfedilen bu mutasyonun, bakterilere karşı vücudu zayıflatırken, virüslere karşı tam bir bağışıklık sağladığı belirtiliyor. Burun damlası şeklinde uygulanan ilaç, deneklerde grip, kızamık, su çiçeği ve Covid-19'a karşı bağışıklık geliştirdi. Virüsle savaşan proteinlerin aktif hale gelmesi sağlansa da, bu proteinlerin miktarı henüz yeterli düzeyde değil.
BİLİNMEYEN VİRÜSLER İÇİN UMUÇ
Araştırmanın gelecek hedefleri arasında, bilinmeyen virüslere karşı koruyucu damlalar üretmek ve böylece pandemi riskini azaltmak yer alıyor. Öte yandan, İngiltere'de yapılan bir başka araştırmada, laboratuvar fareleri yerine yassı solucanların kullanılmasıyla hayvan deneylerinde kemirgen kullanımının azaltılması hedefleniyor. Reading Üniversitesi araştırmacıları, solucanların, akıl sağlığı sorunlarının tedavisinde kullanılan 'haloperidol' ilacına laboratuvar fareleriyle benzer tepkiler verdiğini keşfetti. 2023 İngiltere verilerine göre, hayvan araştırmalarında yaklaşık bir milyon kemirgen kullanılmış ve sinir bilimi araştırmalarında fare kullanımı yüzde 20'lerden yüzde 50'lere çıkmıştı. Yassı solucanların kullanımıyla deneylerde kullanılan kemirgen sayısının azaltılabileceği düşünülüyor.
- 10:09Bodrum'dan Altınordu'ya bir yetenek daha
- 10:07Eski başpehlivan İbrahim Gümüş'ün vefatı spor camiasında büyük üzüntü yarattı
- 09:57Söğütspor'dan dev derbi zaferi: Lideri deplasmanda devirdiler!
- 09:47Genç tasarımcılardan doğal taşla yaratıcı dokunuşlar
- 09:37Bursa'da üst geçitten kopan demir, trafiği birbirine kattı: Faciadan dönüldü!




